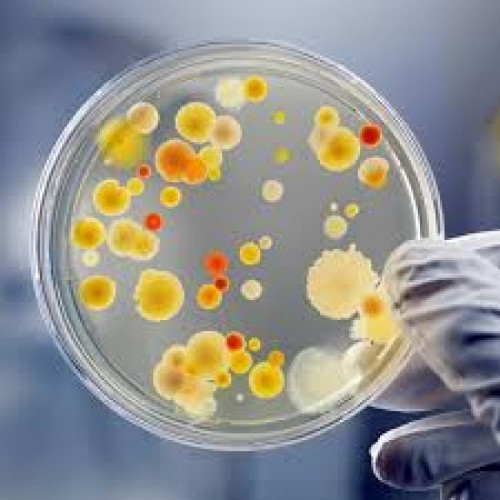
Уреаплазма: риски для фертильности и беременности фото

Уреаплазма: ризики для фертильності та вагітності
Уреаплазма относится к классу бактерий, известных как микоплазмы, — это самые маленькие из известных организмов в своем роде. У уреаплазмы отсутствует клеточная стенка, что делает ее уникальной среди бактерий. Есть два вида уреаплазмы: Ureaplasma urealyticum и Ureaplasma parvum. На самом деле большинство людей инфицированы уреаплазмой, но не подозревают об этом, поскольку, находясь в гармонии с другими бактериями в организме, она не вызывает никаких симптомов. В некоторых случаях уреаплазма связана с заболеваниями, поражающими женскую и мужскую репродуктивную систему. Она также может быть опасна во время беременности и заражать новорожденных.
Как передается уреаплазма?
Уреаплазменная инфекция передается половым путем, а также вертикально от матери к плоду во время беременности или родов. Она очень распространена среди сексуально активных женщин (80%), но, согласно научным исследованиям, ею могут болеть и пациенты, никогда не жившие половой жизнью (40%).
Ureaplasma urealyticum чаще передается половым путем и вызывает симптомы, в то время как Ureaplasma parvum ведет себя как комменсальная бактерия, то есть не вызывает дискомфорта или заболевания.
Какие признаки уреаплазменной инфекции?
Как уже упоминалось, уреаплазма не вызывает симптомов, если мирно сосуществует с другими бактериями. Здоровая иммунная система может контролировать их распространение, предотвращая развитие инфекций. Однако популяция уреаплазмы быстро увеличивается при падении иммунитета.
Бактерия может влиять на количество сперматозоидов и их подвижность у мужчин. Уреаплазма бывает причиной уретрита и бактериального вагиноза. Уретрит - воспаление канала, по которому моча из мочевого пузыря выводится наружу, вызывает боль или жжение во время мочеиспускания, зуд вокруг уретры и необычные или зловонные выделения. Бактериальный вагиноз - инфекция влагалища, которая проявляется неприятным запахом или необычными выделениями из влагалища, зудом во влагалище и вокруг него, а также жжением во время мочеиспускания, болью в области таза или живота.
Уреаплазма у беременных и новорожденных
Передача уреаплазмы от матери плоду во время беременности ведет к:
• выкидышу;
• преждевременному разрыву плодных оболочек;
• преждевременным родам;
• мертворождению.
Недоношенные дети более восприимчивы к уреаплазменной инфекции, особенно, если их вес при рождении составляет менее 1 кг. В частности, у них могут развиться: пневмония; менингит и поражение головного мозга; повреждение легких и проблемы с дыханием.
Как лечить?
Инфекции урогенитального тракта можно лечить азитромицином, доксициклином или фторхинолонами. В любом случае, врач Репродуктивного центра «Благодар» оценит ваш конкретный случай и назначит наиболее подходящую терапевтическую стратегию. Во время лечения антибиотиками до полного выздоровления следует воздержаться от половой активности, а также назначить терапию партнеру, независимо от наличия специфических симптомов.
Если инфекция не будет адекватно вылечена, она может негативно повлиять на фертильность. У пациентов с ослабленной иммунной системой уреаплазменная инфекция способна распространяться на почки и кости.
Как предотвратить заражение уреаплазмой?
Рекомендации по профилактике уреаплазменной инфекции: соблюдение интимной гигиены; избегание ношения синтетического нижнего белья и обтягивающих брюк; избегание использования ароматизированных средств для интимной гигиены; использование чистых секс-игрушек. Также важно избегать незащищенных половых контактов, особенно, если один из партнёров проходил лечение от уреаплазмы менее 7 дней. Также важно проводить своевременное лечение заболеваний мочеполовой системы и регулярно проходить профилактические осмотры.
Мы всегда
рады Вам помочь!
